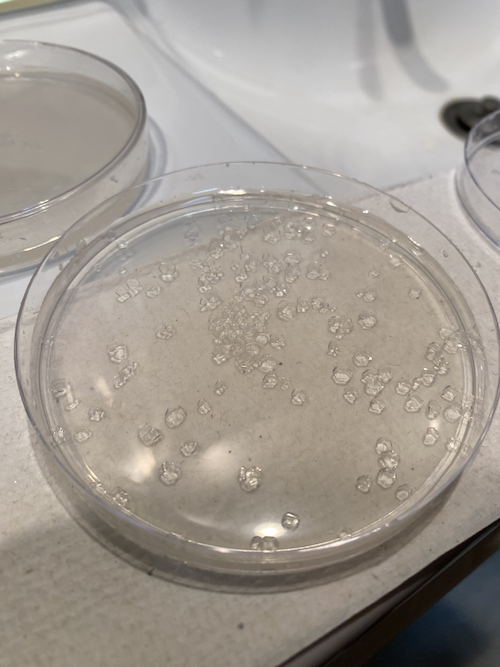

Textile Scaffold¶
What I Made This Week¶
References + Inspiration¶
I didn't know what to expect from this week but I have to say the topic is quite enlightening. I never truly saw the relationship between textiles and architecture and frankly any other industry like automotive or aerospace (one of my personal favorites) until this week's lecture. Needless to say, it was pretty wicked cool.
I'm also a huge fan of composites, which are materials that combine more than 1 element and can achieve hybrid material properties. They're super versatile. Composites are also defined as formed by a matrix (resin) and a reinforcement of natural fibers.
So when I learned of composites but in the bio realm it immediately piqued my interest.
Paper making is a rather in-depth craft. Art, to say the least. And many origami enthusiasts and artists are very particular about the paper they use. For good reason, quite honestly.
Anastasia presented this really beautiful work called BioFold, where the paper, which is made for interior walls, is made of 50% jute coffee bags from coffee roasters in Amsterdam and the Zaanstreek and other 50% are PLA fibers, a biodegradable plastic.
If BioFold is making strides to bring this biocomposites to interiors it's supremely indicative of the future of materials and design. It's such an amazing and innovative way to rethink design and sustainability.
Neri Oxman, while at MIT, developed programmable water-based biocomposites under a project entitled Aguahoja for digital design and fabrication.
The marriage of material chemistry and digital fabrication here is extraordinary.
Biocomposites are things of the future, really. They've been practiced since the beginning of human civilization. That's what I find most intriguing. It's an old practice that is now using new tools.
Perhaps it's because I love hats and wearing them that I'm fascinated by crowns and large head pieces.
I love looking at headdresses. They're so intricate and beautiful. I thought I could create a kind of headpiece with crystals.
Along that same vein, I love liberty spikes popularized in the 1970s punk movement. Liberty spikes actually have a Celtic history. Celtic warriors around 1000 BC in Britain wore spiked hair to appear fearsome in battle.
Being able to crystallize these shapes or fibers like this 19th century dress would prove interesting and inspiring.
Weekly Assignment
- Document the concept, sketches, references also to artistic and scientific publications
- Produce 2 techniques of textile scaffold choosing from the following:
- fabric formwork with casting
- crystallization
- wood-textiles composite
- resin & bioresin -textiles composite
- leather molding
- other
- Document the process including the step-by-step instructions on software, machine, mold making, vaccum forming and textile composites
- Upload your design and fabrication files, including the 3D model and CAM file when possible
- Document at least 2 processes from design to prototyping, fabrication, materials used, document your achievements and unexpected outcomes
- Make a stop motion of your crystal growth or use 3D modeling software to simulate your design (extra credit)
What You'll Need
NOTE: You don't need all of these. Just depends on your needs. * 3D scanner or scanning software * CNC milling machine * Vacuum forming machine * Laser cutter * 3D Printer * CAD software: Rhinoceros, Grasshopper, Solidworks, Fusion360 * CAM software: RhinoCAM, FusionCAM * Wooden blocks (for CNC milling) * Resins (polyester, epoxy, bio resin) * Gelatine, cornstarch, agar agar (for bio-composites) * Fabrics (lycra fabrics, bleed fabric) * Textile hardner (for composites) * Vacuum bags (for composites) * Concrete (for casting) * Alum, Rochelle salt, Potassium sodium, Epsom Salt, Sugar (for crystallization)
Paper Making¶
I've always had a fascination with paper and when I found there's a whole field that experiments with paper, electronics, and interactivity, my jaw dropped.
Anyway, this week I dove into making paper from textile scraps + paper trash + chamomille tea bags I had. I would have used saw dust if I was in a woodshop.
Tools¶
- Textile scraps
- Paper scraps
- Wood scraps (saw dust, etc.)
- Water
- Blender
- Mold and deckle
- Plastic Bin
- Sponge
- Cooching sheets (cotton fabric sheets)
- Laser cutter
Recipe¶
- Shred your miscellaneous scraps into small pieces by hand or with a shredder.
- Prepare a bin and fill it with water. This will be your dipping bin.
- For every 1 cup of scraps use 3 cups of water. So that said, put your desired amount of scraps in a blender and its proportional amount of water. Blend until the mixture is smoothie-like, no visible large pieces. This is your pulp.
- Pour your pulp into a container, could be another plastic bin. I used a pot. If you're making more than one mixture, place each pulp in its own respective plastic bin. If your blender is like mine and isn't as strong to handle something like this, blend small palm fulls of material with water at a time.
- Scoop some handfuls of pulp into your dipping bin (with water from step 2). How many handfuls you put will affect the thickness of your paper so start with 2-3. Swish the water + pulp around so the particles don't settle at the bottom.
- Dip your mold and deckle into your dipping bin, rock it gently top to bottom, and pull it straight up from the water + pulp mixture. Let the water drain.
- Take your mold off and place your "paper" face (still on the deckle) down on your damp or somewhat damp cooching sheet.
- Sponge out the excess water on the mesh of the deckle and peel off deckle frame.
- Lay your "paper" + cooching sheet flat or hang it on a rack to dry overnight.
- Once dry, you can remove the paper from the cooching sheet. If it's curled, put it under some heavy books to flatten.
- And you're ready to go! In my case, I'm ready to lasercut! :D
Textile Waste Paper - Foldable Packages¶
The above pictures show making the pulp. I should have put a picture of the blender but like I wrote in the recipe, if you have a sensitive blender like mine, it's best to blend small palmfuls at a time with water. AND be sure to cut your scraps even smaller than you see I did above. Almost like diced onion.
- Damp cooching sheet
- Water + pulp mix
- Mold & deckle face down on sheet
- Sponge as much water out of "paper" as possible
- Drying on sheet overnight!
I wanted to design some foldable packages using my new paper. Package design is a huge field within engineering and design. It's quite complex but fascinating.
Here are the papers dried! I really like the colors that resulted.
And here they are lasercut and folded. I hope to use a different kind of textile waste next time because inevitably this kind of comes out and lasercuts like a kind of felt variant but I have so much leftover wool I wanted to throw it in there.
Crystallization¶
Now, crystallization is a simple recipe BUT it's also very delicate. Boy, do I know. So, I wanted to clarify any things that honestly confused me throughout the process.
HELPFUL NOTES! - There's various "Alums" but the one you need is 100% Potassium Aluminum Sulfate and yes it's the same alum you use to mordant your fabrics to dye.
- There is a ratio you could try to make your crystals and that's 2 tbsp. of alum per 1/2 cup of hot water. You could try this but the optimal crystal-making method is to make a super saturated solution of alum and water. Now because I had limited amount of alum before I had to buy more I was honestly trying to ration but, uh, you can't do that. It's frustrating, believe me, because you can dissolve so much more alum in a cup of hot water and you go, "will this madness ever end??" Just stay with it. Once alum powder settles at the bottom and doesn't dissolve anymore you're good.
This is what the alum solution should look like. A few salts at the bottom that can no longer dissolve.
-
Seed crystals are crystals that grow without any object in the solution. Crystals form easily on top of seed crystals that encourage larger crystals on top of each other or object BUT you don't have to use them. I'm using them for attatching them to my hair clips and LEDs.
-
If your solutions isn't saturated enough, no worries! You can take your current solution, reheat it to hot but not to boiling and add more alum until no more can dissolve.
Tools¶
- Alum
- Pencil or wooden popsicle stick
- Spoon
- Clean beakers or jars
- Petri dishes
- Fishing line or thread
- Distilled Water (you don't need to use this but I thought it'd be cool to try!)
- Hair clips, plants, LEDs, etc.
Crystallized Process¶
I've had varying degrees of success with crystallization but here are my findings and results. Hopefully they help you!
Hair Clip + LED Crystal Growing¶
SEED CRYSTAL GROWING:
- Slowly add alum to 1/2 cup of very hot distilled water (but not boiling), stirring to dissolve, in a clean beaker. You can make as much as you want but I'm putting this in a petri dish.
- Keep adding the alum until no more will dissolve: this is your saturated solution.
- Use a coffee filter to filter your alum saturated solution through.
- Pour a little bit of this solution into a petri dish and let it sit undisturbed several hours or overnight or longer if you want more or less crystal growth.
USING YOUR SEED CRYSTAL ON TOP OF HAIR CLIPS AND LEDS:
It's recommended to suspend your crystal and not allow it touch any part of your container but based my research and on Loes Boger's documentation to not crystallize certain areas of your object, I determined adding hot glue to areas I didn't want to crystallize or laying an object flat on the bottom would maybe prove successful.
- Take a one of your seed crystals grown in the section above and set aside.
- Make another saturated alum solution, adding alum until no more alum can dissolve.
- Use a coffee filter to filter your alum saturated solution through.
- Add hot glue to sides of hair clips that you don't want crystals to grow on and hot glue seed crystal on top of your hair clips if you decide. Also hot glue seed crystal on top of each LED.
- Add a few drops of food coloring if you'd like to change the color of your crystals.
- Place your hair clips and LEDs with seed crystals on top in your solution when it's lukewarm. Too hot, the seed crystal will dissolve, to cold and the crystals have already started forming.
- Cover your container with a paper towel to keep out the dust and let your crystal grow until you are happy with its size. When you take it out of the solution, set it on some plastic wrap or paper towel to dry.
These clips are not porous so I should've really known and thought okay well seed crystals need to be attached to them to have crystals grow on them. Anyway, next time!
There were no crystals growing on the LEDs but again that's because after some time experimenting and not having seed crystals until now, I just decided to put LEDs in the solution without anything else. BUT now I hot glued a seed crystal to each LED so we'll see how that turns out.
Crystals formed on my neopixels finally!
One ended up breaking when I was soldering leads to the pads so FYI to be extra careful when soldering to your crystal encrusted neopixel.
Simple Code for Nepixel on Arduino UNO!
#include <Adafruit_NeoPixel.h>
#define PIN 6
#define NUMPIXELS 1 // number of pixels
Adafruit_NeoPixel pixels = Adafruit_NeoPixel(NUMPIXELS, PIN, NEO_GRB + NEO_KHZ800);
void setup() {
pixels.begin();
}
void loop() {
pixels.clear(); // turn off pixels
// set blue-purple color neopixel
pixels.setPixelColor(0, pixels.Color(255, 0, 255));
pixels.show(); // show color
}
Crystals on the tulle did not result conductive so more experimentation on my part is needed for that.
HANGING YOUR SEED CRYSTALS:
You can choose to suspend your crystals on a piece of thread or fabric, etc.
Just tie fishing line or thread to the seed crystal. Tweezers might help. If you need to, you can score a groove in the crystal to hold the line in place.
Tie the other end of the fishing line to a pencil, then set the pencil across the top of the jar so the seed crystal is suspended in the alum solution without touching the sides or bottom of the jar.
Tulle Conductive Crystals¶
I wanted to make conductive crystals on some tulle fabric from the Computational Couture week! :)
Tools¶
- 2 tsp of Bare Conductive Black Ink
- Boiling water
- Alum
- Fishing line or thread
- Wooden stick or pencil
- Substrates like textiles, yarns, etc.
Boil water and add 100g of alum. Stir until super saturated and the powder is no longer dissolving. Add 1-2 tsp. of Bare Conductive ink and stir. Crystals form bigger when it cools down slower.
Wait 12 hours, take out the crystal, reheat the solution and add 3-4 more tablespoons of alum to saturate it more. Wait for it to cool down before putting the crystal back in or you might dissolve it. You basically give it more food to grow.
Wait another 12 hours and take it out. Continue the 12 hour cycle replenishing the solution with alum depending on how big you want the crystals to grow.
I didn't suspend this enough. I was trying to crystallize only the middle but I need a larger container.
I threaded a conductive thread, in and out, in the middle of my square tulle fabric sample and tied knots to make a ruffle.
Still no crystals on the tulle but 2 crystals did grow on the bottom. Not black either so that's a little strange.
I'm trying once again with the tulle and added the 2 crystals on top of the tulle in the petri dish to act as seed crystals. Hopelly better results.
I really like how it turned out! It needed more time and more experimentation to actually be conductive but I think it looks pretty!
Crystallizing Plants¶
Like I said, you don't need seed crystals necessarily. You can use the same alum solution recipe, wait for it to be lukewarm, and submerge your plant stem in it like I did here.
I wanted to submerge and crystallize lavender but 'twas not to be. It's actually quite buoyant and maybe I shouldn't be surprised but I am. Anyway, the water is a bit gray due to residual conductive black ink in the pan I used to heat the distilled water once again. We'll see how it comes out!
Files¶
- Package Design 1: packagedesign1.dxf
- Package Design 2: packagedesign2.dxf
References¶
- Paper Making Video
- Paper Making Another Video
- Loes Bogers Fabricademy Website
- Marisa Satsia's Fabricademy Website